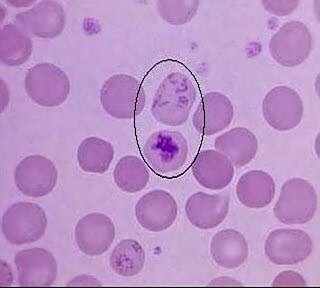

中值细胞比率低意味着什么
来源:网络收集 点击: 时间:2024-03-31中值细胞数目低就说明体内有病菌感染,不过百分比正常的话不用管的。如果有感冒的症状,这个中性粒细胞偏低提示病毒感染。
如果没有任何症状,这个检查结果没有意义。另外红细胞积压轻度异常,没有临床意义。如果白细胞正常,中性稍高一点,就不太要紧。中值细胞又称中间细胞(MID)是嗜酸、 嗜碱及单核细胞之和。
反应性增高:见于过敏性疾患、寄生虫病、某些皮肤病,如湿疹、天疱疮、银屑病、剥脱性皮炎等,某些传染病如猩红热。 肿瘤性增高:见于淋巴系统恶性疾患,如霍奇金病;上皮系肿瘤,如肺瘤;血液病,如慢性粒细胞白血病、嗜酸粒细胞性白血病。
中值细胞简介:
中值细胞又称中间细胞(MID)是嗜酸、 嗜碱及单核细胞之和。
一、嗜酸粒细胞增高的临床意义
1. 反应性增高:见于过敏性疾患、寄生虫病、某些皮肤病,如湿疹、天疱疮、银屑病、剥脱性皮炎等,某些传染病如猩红热。
2. 肿瘤性增高:见于淋巴系统恶性疾患,如霍奇金病;上皮系肿瘤,如肺瘤;血液病,如慢性粒细胞白血病、嗜酸粒细胞性白血病。
二、嗜碱粒细胞增高的临床意义
1. 生理性增多:见于出生后2周的婴儿,儿童亦可较成人高。
2. 病理性增多:某些感染,如亚急性感染性心内膜炎、疟疾、黑热病、急性感染的恢复期、活动性结核等;某些血液病、粒细胞缺乏症恢复期、恶性组织细胞病、恶性淋巴瘤、急性单核细胞性白血病。
3.中值细胞比率偏高,一般白细胞也会高,说明有细菌感染引起的炎症.如果白细胞正常,中性稍高一点,也不要紧.不过是可以通过食疗法治疗的。
4.中值细胞低的话,可能导致免疫力低下,以合并其他炎症感染.常见于病毒感染,药物使用,抗癌药物治疗,严重感染.再障,粒细胞缺乏等。
参考资料:百度百科中值细胞
版权声明:
1、本文系转载,版权归原作者所有,旨在传递信息,不代表看本站的观点和立场。
2、本站仅提供信息发布平台,不承担相关法律责任。
3、若侵犯您的版权或隐私,请联系本站管理员删除。
4、文章链接:http://www.ff371.cn/art_390129.html
订阅